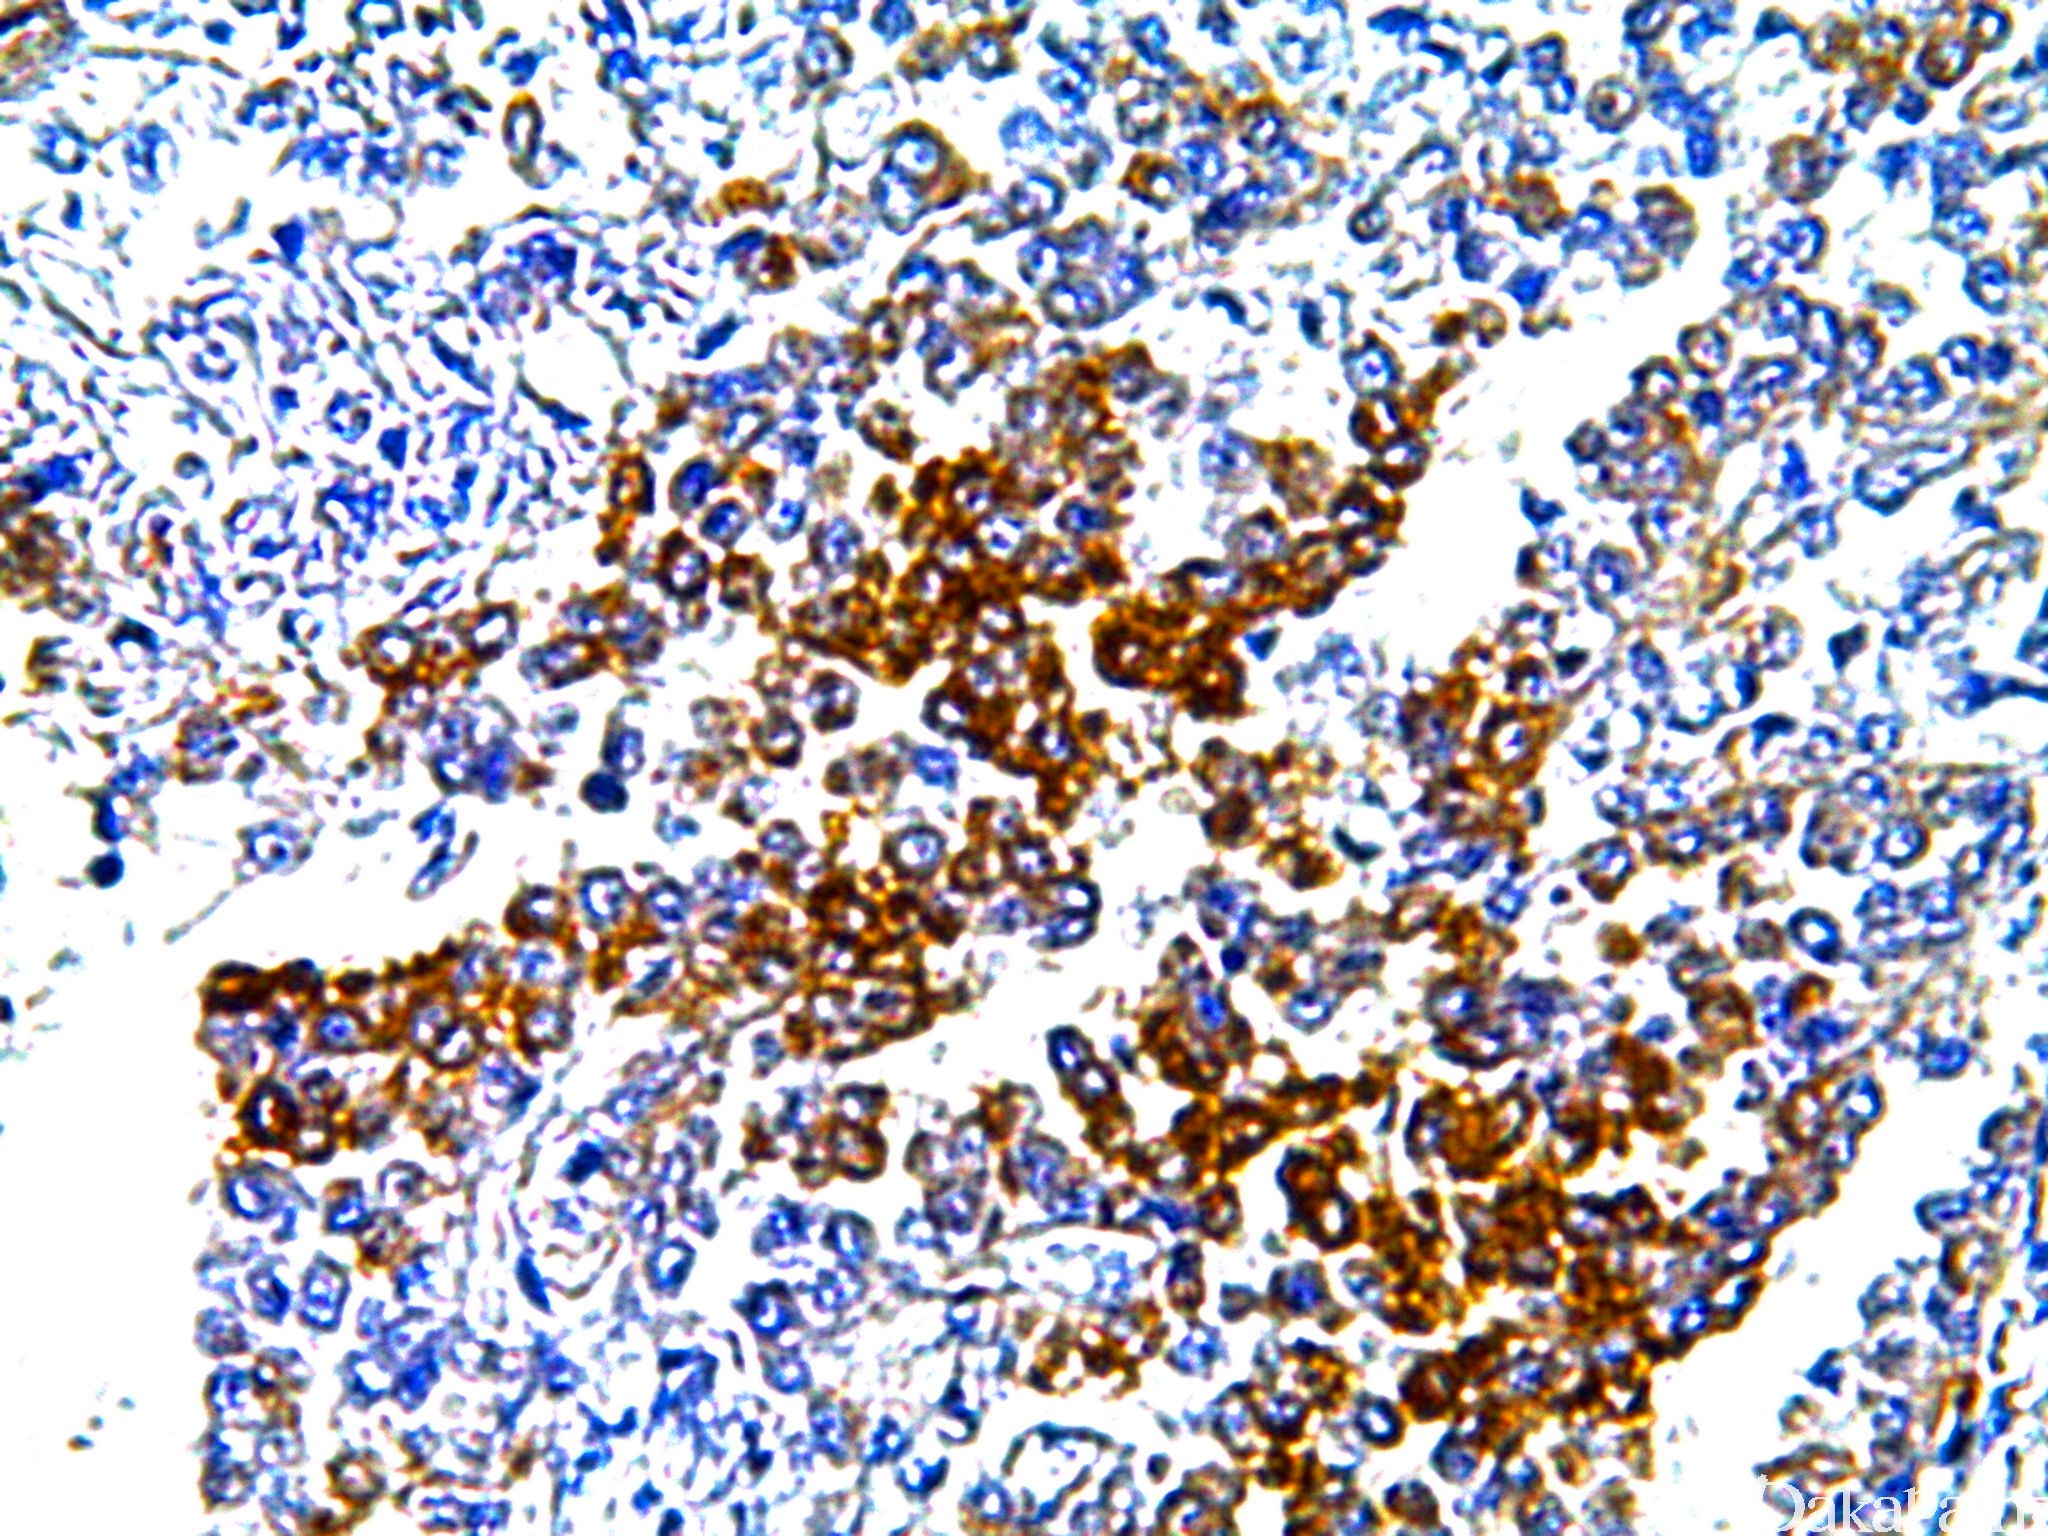

GLUT1
概述:
人红细胞葡萄糖转运蛋白,转载葡萄糖进入上皮细胞,为哺乳动物特有的葡萄糖转运蛋白家族成员之一。正常表达在红细胞、睾丸和生殖细胞、肾小管、内皮细胞等。
信号定位: 胞膜
在病理学中的应用:
1.97%幼年性毛细血管瘤内皮细胞阳性而血管畸形不表达,可用于两者的鉴别诊断。
甲状腺间变性癌与滤泡性癌的鉴别诊断;
乳头状肾细胞癌与透明细胞乳头状肾细胞癌的鉴别;
4、体腔积液细胞学诊断良(-)恶(+)性的鉴别;
5、良恶性间皮瘤的鉴别诊断,良性间皮瘤一般阴性;
7、常强表达于结直肠癌;
- 胸腺癌(常阳性)与胸腺瘤(常阴性)的鉴别;
9、可作为乳腺癌患者对激素治疗反应性标记。
商品化试剂(排名不分先后,本网站对抗体质量不负责!)
公司 | 克隆号 | 即用型(ml) | 原液(ml) | ||||
基因科技 | Poly | / | 2 | 4 | 7 | / | 0.2 |
赛诺特 | 多克隆 | 1 | 3 | 6 | / | 0.1 | 0.2 |
中杉金桥 | / | 1.5 | 3 | 6 | / | 0.1 | 0.2 |
安必平 | / | 1.5 | 3 | 6 | / | 0.1 | 0.2 |
福建迈新 | 多克隆 | 1.5 | 3 | 6 | / | / | 0.2 |
在肿瘤中的表达情况:
几乎全部阳性(≥95%的病例阳性): 透明细胞肾细胞癌、甲状腺癌显示胸腺样分化、甲状腺间变性癌、神经纤维瘤、肺鳞状细胞癌
通常阳性(<95%,≥75%的病例阳性): 透明细胞乳头状肾细胞癌、神经鞘膜瘤,NOS、间皮瘤,NOS、肾细胞癌、乳腺导管原位癌、甲状腺乳头状癌、神经束膜瘤、甲状腺低分化癌、输卵管腺癌、间皮瘤,双向分化
经常阳性(<75%,≥55%的病例阳性): 子宫内膜腺癌 I-II 级、子宫平滑肌肉瘤、上皮样间皮瘤、甲状腺滤泡性癌、乳腺浸润性癌,非特殊类型
有时阳性(<55%,≥35%的病例阳性): 局限性恶性间皮瘤、胆管癌、肺腺癌
少数阳性(<35%,≥15%的病例阳性): 平滑肌肉瘤,NOS、恶性外周神经鞘膜瘤、胸腺瘤,B3、血管肉瘤
偶尔阳性(<15%,≥5%的病例阳性): 乳头状肾细胞癌、甲状腺滤泡性腺瘤、间皮增生
几乎全部阴性(<5%的病例阳性): 鞋钉样血管瘤、血管内皮瘤,NOS、血管内皮细胞瘤,Kaposi 型、淋巴瘤、巨细胞血管母细胞瘤、高分化乳头状间皮瘤、脑膜瘤,分泌性